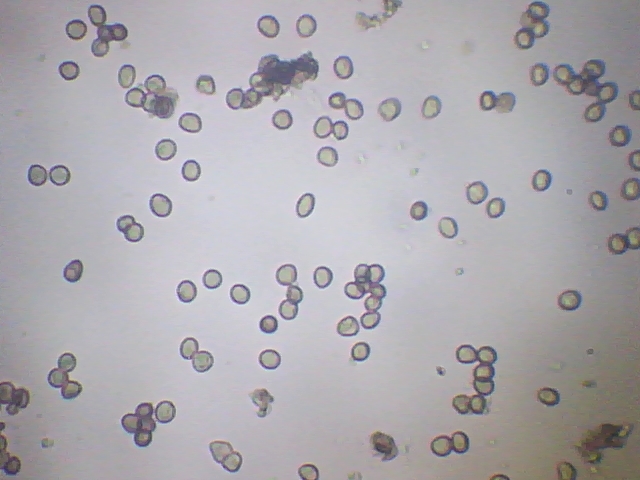

- Foro
- Foros sobre Micología de fungipedia
- Fotografía micológica
- Physarum bitectum (Espectacular especie)
×
La idea es que nos puedas mostrar tu trabajo fotográfico y sobre todo nos expliques como lo has realizado, de esta forma todos podremos aprender un poco más del resto. También puedes colocar y solicitar información sobre fotografía (manuales, características de componentes, retoques etc).
 Physarum bitectum (Espectacular especie)
Physarum bitectum (Espectacular especie)
- javier
-
 Autor del tema
Autor del tema
- Fuera de línea
- Moderador
-

Menos
Más
- Mensajes: 5617
- Gracias recibidas: 4356
10 años 4 meses antes - 10 años 4 meses antes #82467
por javier
 Hola chicos, he dudado mucho entre la que os propongo Physarum bitectum y la Physarum cinereum pero creo que encaja mejor la que puse en el título del post, de todas formas puedo estar equivocado así que cuento con vuestra grata ayuda....bueno hay voy.
Hola chicos, he dudado mucho entre la que os propongo Physarum bitectum y la Physarum cinereum pero creo que encaja mejor la que puse en el título del post, de todas formas puedo estar equivocado así que cuento con vuestra grata ayuda....bueno hay voy.
Otra lignicola que son mi devilidad. Sobre madera de encina, el tamaño total del conjunto debía de ser de unos 10 centímetros de largo por unos 7 de ancho, de color blanco, de consistencia seca ,estrechas, en su mayoría alargadas haciendo formas de todo tipo. Bueno no me enrrollo más...una imágen vale mas que mil palabras.
Unas imágenes micro por si esto ayuda a certificar la especie propuesta.
Se me ha pasado la siguiente foto-macro realizada con luz incidente a 40x por si sirve para separarla de sus especies próximas.
Deseo que os guste, salu2
Physarum bitectum (Espectacular especie) Publicado por javier
Otra lignicola que son mi devilidad. Sobre madera de encina, el tamaño total del conjunto debía de ser de unos 10 centímetros de largo por unos 7 de ancho, de color blanco, de consistencia seca ,estrechas, en su mayoría alargadas haciendo formas de todo tipo. Bueno no me enrrollo más...una imágen vale mas que mil palabras.
Unas imágenes micro por si esto ayuda a certificar la especie propuesta.
Se me ha pasado la siguiente foto-macro realizada con luz incidente a 40x por si sirve para separarla de sus especies próximas.
Deseo que os guste, salu2
Última Edición: 10 años 4 meses antes por javier.
Por favor, Identificarse para unirse a la conversación.
- Josep Torres
-

- Fuera de línea
- Moderador
-

Menos
Más
- Mensajes: 8739
- Gracias recibidas: 8378
10 años 4 meses antes #82510
por Josep Torres
Respuesta de Josep Torres sobre el tema Physarum bitectum (Espectacular especie)
Gracias Javier  , cada vez te superas más , si las lignícolas son tu debilidad a mí me emocionan. creo que la tienes bien identificada, aunque yo por desgracia aún no me la he encontrado
, cada vez te superas más , si las lignícolas son tu debilidad a mí me emocionan. creo que la tienes bien identificada, aunque yo por desgracia aún no me la he encontrado 
Un abrazo
Un abrazo
El siguiente usuario dijo gracias: javier
Por favor, Identificarse para unirse a la conversación.
- Javi Calvo
-

- Fuera de línea
- Spammer
-

Menos
Más
- Mensajes: 7009
- Gracias recibidas: 2955
10 años 4 meses antes #82512
por Javi Calvo
Respuesta de Javi Calvo sobre el tema Physarum bitectum (Espectacular especie)
Realmente es una especie espectacular, los Myxomycetes dan mucho juego, como les cojas el gusto te vas a enganchar.......  saludos campeón y gracias por deleitarnos con esta chulada.
saludos campeón y gracias por deleitarnos con esta chulada. 
El siguiente usuario dijo gracias: javier
Por favor, Identificarse para unirse a la conversación.
- javier
-
 Autor del tema
Autor del tema
- Fuera de línea
- Moderador
-

Menos
Más
- Mensajes: 5617
- Gracias recibidas: 4356
10 años 4 meses antes #82536
por javier
Respuesta de javier sobre el tema Physarum bitectum (Espectacular especie)
Gracias compañeros por las respuestas, la verdad es que no esperaba para nada encontrarme con algo así, y es eso lo que me mola, que salgo sin nada y casi seguro que vuelvo con especies interesantes...ha...y tengo algo mas por ahí que ya pondré
salu2 y repito...gracias
salu2 y repito...gracias
El siguiente usuario dijo gracias: Josep Torres
Por favor, Identificarse para unirse a la conversación.
- jon joseba arnedo
-

- Fuera de línea
- Moderador
-

Menos
Más
- Mensajes: 3702
- Gracias recibidas: 3555
10 años 4 meses antes #82545
por jon joseba arnedo
 una autentica chulada Javier, no tenia ni la mas remota idea de la existencia de esta especie, gracias por mostrarnosla
una autentica chulada Javier, no tenia ni la mas remota idea de la existencia de esta especie, gracias por mostrarnosla
un saludo
Respuesta de jon joseba arnedo sobre el tema Physarum bitectum (Espectacular especie)
un saludo
El siguiente usuario dijo gracias: javier
Por favor, Identificarse para unirse a la conversación.
- javier
-
 Autor del tema
Autor del tema
- Fuera de línea
- Moderador
-

Menos
Más
- Mensajes: 5617
- Gracias recibidas: 4356
10 años 4 meses antes - 10 años 4 meses antes #82573
por javier
Respuesta de javier sobre el tema Physarum bitectum (Espectacular especie)
Gracias Jon Joseba me alegra que te guste la especie. Quiero recordar que hay todo un mundo por descubrir sobre restos de maderas caídas, y sin ir mas lejos, un rato antes tb me encontré con otra interesante especie que para nada me esperaba encontrar, eso sí...era de unas dimensiones pequeñísimas, y que la fotografié sin saber que era, hasta que luego en casa viendo las imágenes descubrí que se trataban de un grupo de Phaeosolenia platensis sobre un trozo caído de rama de alcornoque. Lastima que la cámara/móvil no dió para más, y por ello la mala calidad de la imágen.
Pero agrego un enlace para que os hagáis una idea del aspecto y tamaño:
www.biolib.cz/en/image/id231351/
salu2
Pero agrego un enlace para que os hagáis una idea del aspecto y tamaño:
www.biolib.cz/en/image/id231351/
salu2
Última Edición: 10 años 4 meses antes por javier.
Por favor, Identificarse para unirse a la conversación.
- Foro
- Foros sobre Micología de fungipedia
- Fotografía micológica
- Physarum bitectum (Espectacular especie)
Tiempo de carga de la página: 0.061 segundos

Foro de micología